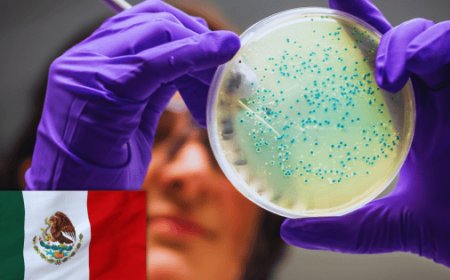
El 70% de los académicos en México: una crisis que frena el avance científico

Todo lo que necesitas saber sobre la Mañanera de Sheinbaum el 29 de abril de 2026

Este miércoles, la conferencia matutina de Claudia Sheinbaum, conocida como 'La Mañanera', trajo consigo información relevante para los habitantes de la Ciudad de México y el Estado de México. En ella, se abordaron temas cruciales como la aplicación del programa Hoy No Circula, un análisis sobre el clima y un análisis del controvertido contexto en Chihuahua. ¿Qué implicaciones tienen estas declaraciones para los ciudadanos? Aquí te lo contamos.
Hoy No Circula: Un alivio o un dolor de cabeza
El programa Hoy No Circula es uno de esos temas que siempre generan opiniones encontradas. Mientras algunos ciudadanos lo ven como un alivio para reducir la contaminación en la Ciudad de México, otros lo perciben como una limitante que complica su movilidad diaria. En la Mañanera de hoy, se confirmaron los detalles de su aplicación para el día, lo que significa que ciertos vehículos no podrán circular. Esta medida, aunque necesaria en términos de salud ambiental, plantea una inevitable pregunta: ¿es suficiente para combatir los niveles de contaminación que aún persisten en nuestra capital?
Hoy, el programa afecta principalmente a vehículos con engomado color amarillo, así como a aquellos que no cumplan con las normas establecidas por las autoridades. Como es usual, las excepciones incluyen vehículos de emergencia, transporte público y aquellos que transportan personas con discapacidad. Sin embargo, para muchos, la idea de no poder utilizar su auto particular no solo representa un inconveniente, sino también un impacto en su economía. Esto nos lleva a pensar en alternativas de movilidad sostenible que puedan ofrecer una solución más duradera.
El clima en CDMX: Preparándonos para el día
En la conferencia, también se presentó el pronóstico del clima para la Ciudad de México. Se anticipan temperaturas que rondarán los 25 grados centígrados, con posibilidad de lluvias por la tarde. Este tipo de clima puede ser un aliado o un enemigo, dependiendo de los planes que cada uno tenga. Para quienes se desplazan en transporte público, las lluvias pueden significar retrasos y una experiencia menos que agradable. Es crucial que las autoridades sigan trabajando en la infraestructura urbana y en la preparación para estos fenómenos naturales, que se vuelven más frecuentes y extremos.
El cambio climático no es un tema distante; afecta nuestra vida cotidiana, desde la calidad del aire hasta cómo planificamos nuestros días.
El lado oscuro de Chihuahua: Un análisis necesario
Un momento delicado de la Mañanera fue el análisis del contexto en Chihuahua, marcado por una serie de controversias y denuncias sobre posibles montajes en las investigaciones policiales. Este asunto no solo es preocupante por las implicaciones legales, sino también por la confianza que los ciudadanos depositan en sus autoridades. ¿Qué ocurre cuando el sistema que debería protegernos se convierte en el mismo que nos pone en riesgo? La transparencia y la rendición de cuentas son más que palabras; son la base de una democracia robusta.
Sheinbaum enfatizó la necesidad de revisar estos casos, lo que sugiere un cambio hacia un enfoque más crítico sobre las prácticas policiales. Sin embargo, queda la pregunta: ¿realmente se implementarán cambios o quedará solo en un discurso político? La respuesta a esto es crucial, ya que habla sobre el futuro de la seguridad y la justicia en el país.
Reflexiones finales sobre la Mañanera
La Mañanera de hoy nos deja varios puntos a considerar. Desde la ejecución del programa Hoy No Circula hasta la preocupación por el clima y el análisis de la situación en Chihuahua, todos estos temas están interconectados. La forma en que nuestras autoridades aborden estos desafíos reflejará no solo su compromiso con la ciudadanía, sino también su capacidad para gestionar los conflictos y crisis que afectan nuestra vida diaria.
Cada conferencia matutina es una invitación a participar en el diálogo sobre el futuro de nuestro país. La información presentada hoy no debe ser vista solo como datos, sino como un llamado a la acción. Los ciudadanos tenemos el poder de influir en las decisiones y en la dirección que tomen nuestros líderes. Así que, mientras esperamos que lleguen tiempos mejores, es esencial que estemos informados y listos para contribuir a la conversación.
Con información de El Informador
Síguenos en canales
Contenido exclusivo, noticias y más